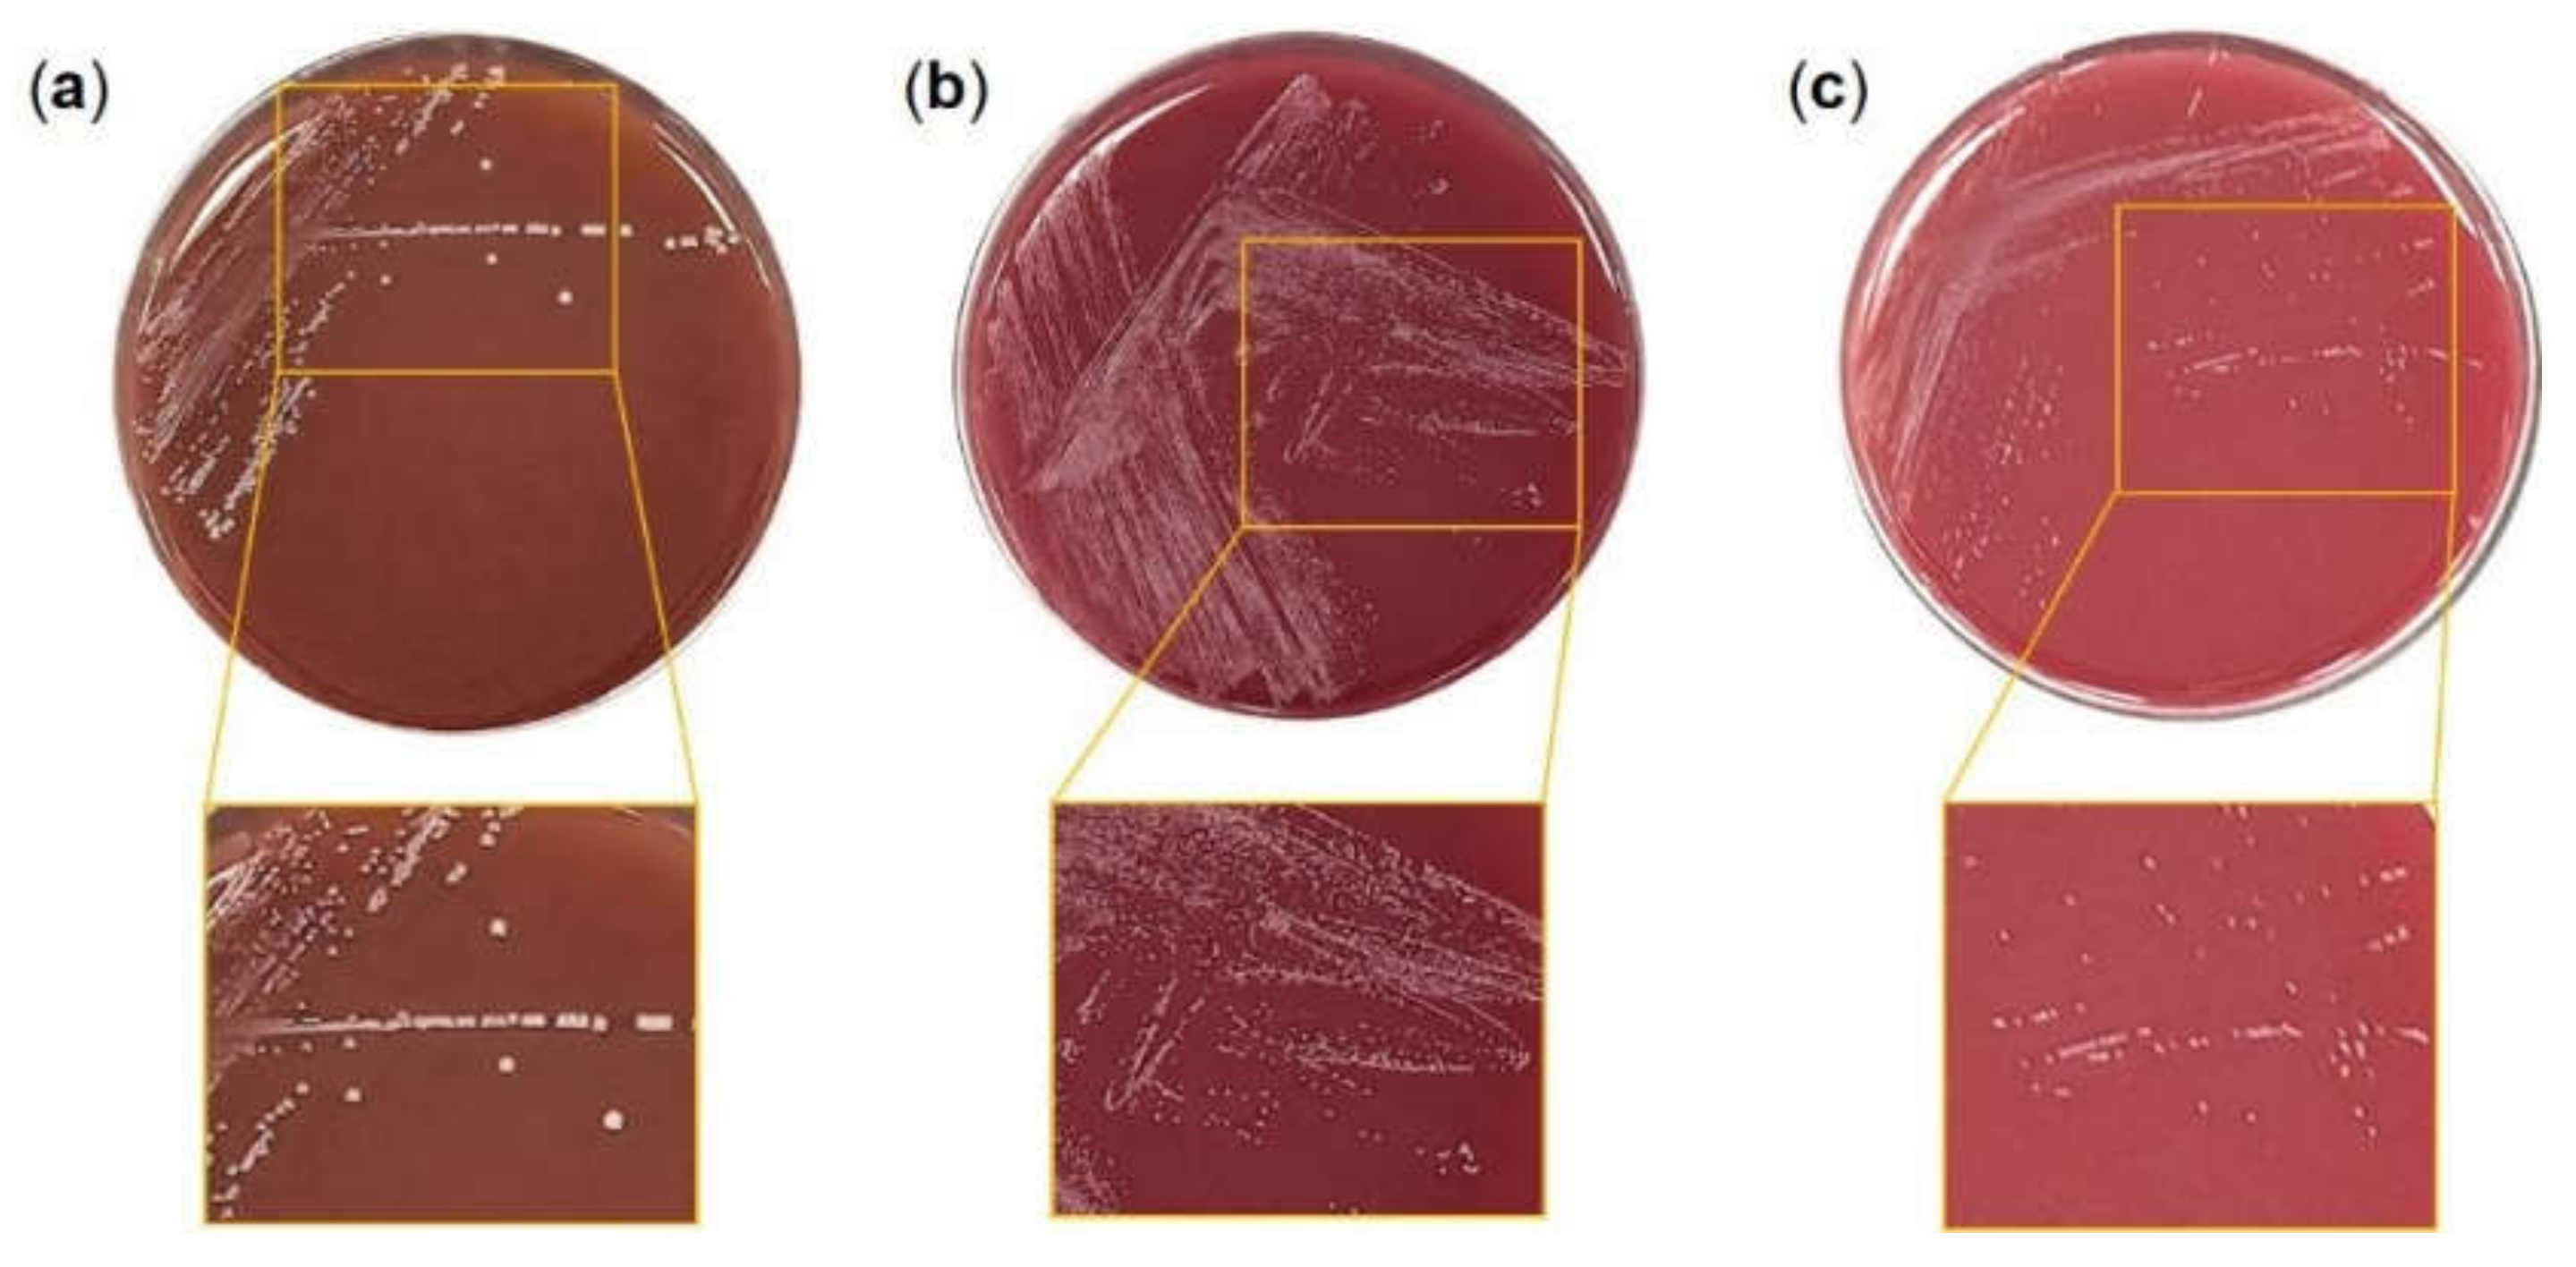
Microorganisms 10 00234 g001

Probiotics Alleviate Oxidative Stress in H2O2-Exposed Hepatocytes and t-BHP-Induced C57BL/6 Mice
Abstract
:1. Introduction
2. Materials and Methods
2.1. Chemicals
2.2. Bacterial Strain Culture and Sample Preparation
2.3. Cell Culture
2.4. Probiotic Properties
2.4.1. Hemolytic Activity
2.4.2. Antimicrobial Susceptibility Test
2.4.3. Adhesion Assay on Intestinal Epithelial Cells
2.5. Cytotoxicity Assay
2.6. Measurement of Lipid Peroxidation and GSH
2.7. Quantitative Real-Time Polymerase Chain Reaction (qRT-PCR)
2.8. Animal Treatment
2.9. Biochemical Parameters
2.10. Statistical Analysis
3. Results
3.1. Safety Test of Probiotics
3.2. Adhesion of Probiotics to HT-29 Cells
3.3. Cytoprotective Effect of Probiotics on H2O2-Exposed Hepatocytes
3.4. Probiotics Elevated Antioxidant Activity in H2O2-Exposed Hepatocytes
3.5. Probiotics Reduced Hepatic Injury in t-BHP-Induced Mice
3.6. Probiotics Increased Antioxidant Activity in the Liver Tissues of t-BHP-Induced Mice
4. Discussion
5. Conclusions
Author Contributions
Funding
Institutional Review Board Statement
Informed Consent Statement
Data Availability Statement
Conflicts of Interest
References
- Rhim, T.-J.; Choi, M.-Y. The antioxidative effects of Rhododendron brachycarpum extracts. Korean J. Plant Resour. 2011, 24, 456–460. [Google Scholar] [CrossRef] [Green Version]
- Jang, M.; Seo, H.L.; Kim, S.C.; Kim, Y.W. Effect of Prunellae Spica on oxidative stress and mitochondrial dysfunction in the hepatocyte. J. Physiol. Pathol. Korean Med. 2016, 30, 20–26. [Google Scholar] [CrossRef]
- Thannickal, V.J.; Fanburg, B.L. Reactive oxygen species in cell signaling. Am. J. Physiol. Lung Cell. Mol. Physiol. 2000, 279, L1005–L1028. [Google Scholar] [CrossRef] [PubMed] [Green Version]
- Hong, I.K.; Park, B.R.; Jeon, G.S.; Lee, S.B. Extraction of flavonoid components from persimmon leaf, thistle and new green. Appl. Chem. Eng. 2016, 27, 276–279. [Google Scholar] [CrossRef] [Green Version]
- Choi, H.-J.; Kim, S.-H.; Oh, H.-T.; Chung, M.-J.; Cui, C.-B.; Ham, S.-S. Effects of Adenophora triphylla ethylacetate extract on mRNA levels of antioxidant enzymes in human HepG2 cells. J. Korean Soc. Food Sci. Nutr. 2008, 37, 1238–1243. [Google Scholar] [CrossRef] [Green Version]
- Wang, Y.; Wu, Y.; Wang, Y.; Xu, H.; Mei, X.; Yu, D.; Wang, Y.; Li, W. Antioxidant properties of probiotic bacteria. Nutrients 2017, 9, 521. [Google Scholar] [CrossRef]
- Kim, H.; Kim, Y.; Kang, C.-H. In vivo confirmation of the antimicrobial effect of probiotic candidates against gardnerella vaginalis. Microorganisms 2021, 9, 1690. [Google Scholar] [CrossRef] [PubMed]
- Jeong, Y.; Kim, H.; Lee, J.Y.; Won, G.; Choi, S.-I.; Kim, G.-H.; Kang, C.-H. The antioxidant, anti-diabetic, and anti-adipogenesis potential and probiotic properties of lactic acid bacteria isolated from human and fermented foods. Fermentation 2021, 7, 123. [Google Scholar] [CrossRef]
- Soccol, C.R.; Vandenberghe, L.P.d.S.; Spier, M.R.; Medeiros, A.B.P.; Yamaguishi, C.T.; Lindner, J.D.D.; Pandey, A.; Thomaz-Soccol, V. The potential of probiotics: A review. Food Technol. Biotechnol. 2010, 48, 413–434. [Google Scholar]
- Zommiti, M.; Chikindas, M.L.; Ferchichi, M. Probiotics—Live biotherapeutics: A story of success, limitations, and future prospects—not only for humans. Probiotics Antimicrob. Proteins 2020, 12, 1266–1289. [Google Scholar] [CrossRef]
- Lee, J.Y.; Kim, H.; Jeong, Y.; Kang, C.-H. Lactic acid bacteria exert a hepatoprotective effect against ethanol-Induced liver injury in HepG2 cells. Microorganisms 2021, 9, 1844. [Google Scholar] [CrossRef] [PubMed]
- Kim, H.I.; Kim, J.-K.; Kim, J.-Y.; Jang, S.-E.; Han, M.J.; Kim, D.-H. Lactobacillus plantarum LC27 and Bifidobacterium longum LC67 simultaneously alleviate high-fat diet-induced colitis, endotoxemia, liver steatosis, and obesity in mice. Nutr. Res. 2019, 67, 78–89. [Google Scholar] [CrossRef] [PubMed]
- Kim, W.-G.; Kang, G.-D.; Kim, H.; Han, M.; Kim, D.-H. Bifidobacterium longum IM55 and Lactobacillus plantarum IM76 alleviate allergic rhinitis in mice by restoring Th2/Treg imbalance and gut microbiota disturbance. Benef. Microbes 2019, 10, 55–67. [Google Scholar] [CrossRef] [PubMed]
- Amaretti, A.; Di Nunzio, M.; Pompei, A.; Raimondi, S.; Rossi, M.; Bordoni, A. Antioxidant properties of potentially probiotic bacteria: In vitro and in vivo activities. Appl. Microbiol. Biotechnol. 2013, 97, 809–817. [Google Scholar] [CrossRef]
- Li, S.; Huang, R.; Shah, N.P.; Tao, X.; Xiong, Y.; Wei, H. Antioxidant and antibacterial activities of exopolysaccharides from Bifidobacterium bifidum WBIN03 and Lactobacillus plantarum R315. J. Dairy Sci. 2014, 97, 7334–7343. [Google Scholar] [CrossRef] [PubMed] [Green Version]
- Escamilla, J.; Lane, M.A.; Maitin, V. Cell-free supernatants from probiotic Lactobacillus casei and Lactobacillus rhamnosus GG decrease colon cancer cell invasion in vitro. Nutr. Cancer 2012, 64, 871–878. [Google Scholar] [CrossRef] [PubMed]
- Buxton, R. Blood agar plates and hemolysis protocols. Am. Soc. Microbiol. 2005, 30, 1–9. [Google Scholar]
- EFSA Panel on Additives and Products or Substances used in Animal Feed; Rychen, G.; Aquilina, G.; Azimonti, G.; Bampidis, V.; De Lourdes Bastos, M.; Bories, G.; Chesson, A.; Cocconcelli, P.S.; Flachowsky, G.; et al. Guidance on the characterisation of microorganisms used as feed additives or as production organisms. EFSA J. 2018, 16, e05206. [Google Scholar]
- Chen, Z.-Y.; Hsieh, Y.-M.; Huang, C.-C.; Tsai, C.-C. Inhibitory effects of probiotic Lactobacillus on the growth of human colonic carcinoma cell line HT-29. Molecules 2017, 22, 107. [Google Scholar] [CrossRef]
- Tolosa, L.; Donato, M.T.; Gómez-Lechón, M.J. General cytotoxicity assessment by means of the MTT assay. In Protocols in In Vitro Hepatocyte Research; Springer: Berlin/Heidelberg, Germany, 2015; pp. 333–348. [Google Scholar]
- Livak, K.J.; Schmittgen, T.D. Analysis of relative gene expression data using real-time quantitative PCR and the 2−ΔΔCT method. Methods 2001, 25, 402–408. [Google Scholar] [CrossRef]
- Kim, D.H.; Kim, M.; Oh, S.B.; Lee, K.M.; Kim, S.M.; Nho, C.W.; Yoon, W.B.; Kang, K.; Pan, C.H. The protective effect of antioxidant enriched fractions from colored potatoes against hepatotoxic oxidative stress in cultured hepatocytes and mice. J. Food Biochem. 2017, 41, e12315. [Google Scholar] [CrossRef] [Green Version]
- Kim, H.; Kim, J.-S.; Kim, Y.; Jeong, Y.; Kim, J.-E.; Paek, N.-S.; Kang, C.-H. Antioxidant and probiotic properties of Lactobacilli and Bifidobacteria of human origins. Biotechnol. Bioprocess Eng. 2020, 25, 421–430. [Google Scholar] [CrossRef]
- Shi, L.H.; Balakrishnan, K.; Thiagarajah, K.; Ismail, N.I.M.; Yin, O.S. Beneficial properties of probiotics. Trop. Life Sci. Res. 2016, 27, 73. [Google Scholar]
- Kim, J.-A.; Lee, Y.S. Role of reactive oxygen species generated by NADPH oxidase in the mechanism of activation of K+-Cl--cotransport by N-ethylmaleimide in HepG2 human hepatoma cells. Free Radic. Res. 2001, 35, 43–53. [Google Scholar] [CrossRef] [PubMed]
- Young, I.; Woodside, J. Antioxidants in health and disease. J. Clin. Pathol. 2001, 54, 176–186. [Google Scholar] [CrossRef] [PubMed] [Green Version]
- Martín, C.; Martínez, R.; Navarro, R.; Ruiz-Sanz, J.I.; Lacort, M.; Ruiz-Larrea, M.B. tert-Butyl hydroperoxide-induced lipid signaling in hepatocytes: Involvement of glutathione and free radicals. Biochem. Pharmacol. 2001, 62, 705–712. [Google Scholar] [CrossRef]
- Oh, J.M.; Jung, Y.S.; Jeon, B.S.; Yoon, B.I.; Lee, K.S.; Kim, B.H.; Oh, S.J.; Kim, S.K. Evaluation of hepatotoxicity and oxidative stress in rats treated with tert-butyl hydroperoxide. Food Chem. Toxicol. 2012, 50, 1215–1221. [Google Scholar] [CrossRef] [PubMed]
- Kang, C.-H.; Kim, J.-S.; Park, H.M.; Kim, S.; Paek, N.-S. Antioxidant activity and short-chain fatty acid production of lactic acid bacteria isolated from Korean individuals and fermented foods. 3 Biotech 2021, 11, 217. [Google Scholar] [CrossRef] [PubMed]
- Chaves, N.; Santiago, A.; Alías, J.C. Quantification of the antioxidant activity of plant extracts: Analysis of sensitivity and hierarchization based on the method used. Antioxidants 2020, 9, 76. [Google Scholar] [CrossRef] [Green Version]
- Wang, L.-X.; Liu, K.; Gao, D.-W.; Hao, J.-K. Protective effects of two Lactobacillus plantarum strains in hyperlipidemic mice. World J. Gastroenterol. WJG 2013, 19, 3150–3156. [Google Scholar] [CrossRef]
- Seth, A.; Yan, F.; Polk, D.B.; Rao, R. Probiotics ameliorate the hydrogen peroxide-induced epithelial barrier disruption by a PKC-and MAP kinase-dependent mechanism. Am. J. Physiol. Gastrointest. Liver Physiol. 2008, 294, G1060–G1069. [Google Scholar] [CrossRef] [PubMed] [Green Version]

| Antimicrobials | Lc. lactis MG5125 | B.bifidum MG731 | B. lactis MG741 | |||
|---|---|---|---|---|---|---|
| MIC (μg/mL) | S/R | MIC (μg/mL) | S/R | MIC (μg/mL) | S/R | |
| Ampicillin | 0.5 | S | 0.016 | S | 0.125 | S |
| Gentamicin | 2 | S | >256 | R | >256 | R |
| Kanamycin | 6 | S | n.r | - | n.r | - |
| Streptomycin | 32 | S | 48 | S | 384 | R |
| Tetracycline | 0.25 | S | 0.38 | S | 3 | S |
| Chloramphenicol | 16 | S | 0.5 | S | 0.75 | S |
| Erythromycin | 0.19 | S | 0.032 | S | 0.16 | S |
| Vancomycin | 0.38 | S | 0.5 | S | 0.5 | S |
| Clindamycin | 0.19 | S | 0.016 | S | 0.016 | S |
| Group | MDA (ng/mL) | GSH (μg/mL) | CAT (mU/mL) | SOD (%) | GPX (mU/mL) |
|---|---|---|---|---|---|
| Normal | 180.19 ± 36.35 b | 1.28 ± 0.07 | 13.39 ± 1.15 a | 92.83 ± 0.19 | 61.60 ± 6.71 |
| t-BHP | 274.00 ± 39.77 a | 1.11 ± 0.06 | 9.71 ± 0.86 ab | 92.60 ± 0.29 | 52.03 ± 3.99 |
| t-BHP + MG5125 | 167.60 ± 27.14 c | 1.13 ± 0.08 | 8.97 ± 1.32 b | 91.95 ± 0.45 | 47.83 ± 6.38 |
| t-BHP + MG731 | 184.04 ± 23.67 b | 1.13 ± 0.10 | 9.40 ± 1.07 b | 92.47 ± 0.29 | 49.43 ± 7.57 |
| t-BHP + MG741 | 185.44 ± 17.11 b | 1.16 ± 0.10 | 10.83 ± 1.69 ab | 92.36 ± 0.16 | 56.30 ± 11.47 |
Publisher’s Note: MDPI stays neutral with regard to jurisdictional claims in published maps and institutional affiliations. |
© 2022 by the authors. Licensee MDPI, Basel, Switzerland. This article is an open access article distributed under the terms and conditions of the Creative Commons Attribution (CC BY) license (https://creativecommons.org/licenses/by/4.0/).
Share and Cite
Lee, J.Y.; Kang, C.-H. Probiotics Alleviate Oxidative Stress in H2O2-Exposed Hepatocytes and t-BHP-Induced C57BL/6 Mice. Microorganisms 2022, 10, 234. https://doi.org/10.3390/microorganisms10020234
Lee JY, Kang C-H. Probiotics Alleviate Oxidative Stress in H2O2-Exposed Hepatocytes and t-BHP-Induced C57BL/6 Mice. Microorganisms. 2022; 10(2):234. https://doi.org/10.3390/microorganisms10020234
Chicago/Turabian StyleLee, Ji Yeon, and Chang-Ho Kang. 2022. "Probiotics Alleviate Oxidative Stress in H2O2-Exposed Hepatocytes and t-BHP-Induced C57BL/6 Mice" Microorganisms 10, no. 2: 234. https://doi.org/10.3390/microorganisms10020234
APA StyleLee, J. Y., & Kang, C.-H. (2022). Probiotics Alleviate Oxidative Stress in H2O2-Exposed Hepatocytes and t-BHP-Induced C57BL/6 Mice. Microorganisms, 10(2), 234. https://doi.org/10.3390/microorganisms10020234






